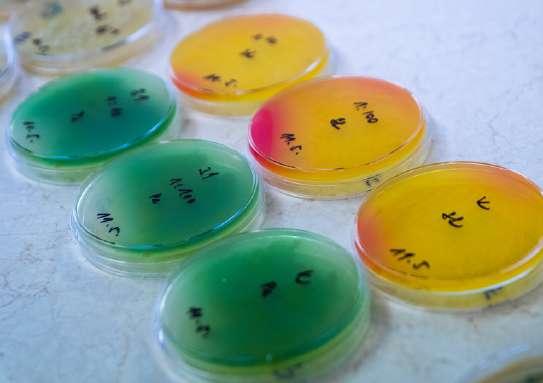

Pomôžeme Ti s adaptáciou Môžes sa vzdelávať a rozvíjať
Ponúkame Ti stabilitu a istotu
Vyskúšaš si všetky aktivity, ktoré vykonáva farmaceut, zapojíš sa do každodenného chodu lekárne a väčšinu času stráviš s pacientami za tárou.
Príď do stánku BENU a zisti, aké sú možnosti ho získať alebo napíš na martina.nemethova@phoenix.sk
Vyber si stáž v BENU a my ťa zoberieme do lekárne, IPL laboratória aj na centrálu.
Ukážeme ti, ako vzniká nová lekáreň.
Naučíme ťa, aké ekonomické ukazovatele sú potrebné pre zdravý chod lekárne.
S nami sa dozvieš čo je Livsane, čo je nové na trhu a ako sa mení správanie zákazníkov.
Otvoríme Ti priestor na uplatnenie priamo v lekárni alebo na oddelení kategorizácie, kvality, logistiky aj marketingu. www.benukariera.sk











popri štúdiu?




skúsenosti v lekárni






U nás môžeš pracovať aj na dohodu s flexibilným pracovným časom podľa tvojho rozvrhu.
Brigáduj v lekárňach Dr. Max, či už ako farmaceutický laborant (podmienkou je maturitná skúška na SZŠ ako farmaceutický laborant) alebo sanitár.
Pre viac infomácií píš na kariera@drmax.sk.
Pridaj sa do našej FB skupiny “Dr.Max Slovensko – pre študentov” a nahliadni do nášho sveta
Poď k nám praxovať a my ti po škole pomôžeme naštartovať kariéru v našich lekárňach. Ako na to?
Stačí si vybrať jednu z viac ako 90 výučbových lekární Dr. Max.
Prejsť riadnym výberovým procesom na niektorú z otvorených pozícií.
Zotrvať v spoločnosti minimálne 1 rok.

Absolvovať celú 5-mesačnú odbornú prax v našich lekárňach.
Stať sa súčasťou Dr. Max najneskôr do 3 mesiacov od úspešného ukončenia štúdia.
Za splnenie podmienok získaš pri prvej výplate odmenu vo výške 1500 €.
Zaujala ťa prax v Dr. Max? Daj nám o sebe vedieť na kariera@drmax.sk alebo vyplň kariérny dotazník na našej stránke.
www.kariera.drmax.sk
v spolupráci
s Farmaceutickou fakultou Univerzity Komenského
Voliteľný predmet pre študentov
Farmácie, 1. – 5. ročník
Spoznaj možnosti kariérneho uplatnenia ako Farmaceut v Dr. Max na centrále v Bratislave alebo v sieti našich lekární. Neváhaj a dohodni si s nami termín svojej Farmaceutickej stáže podľa Tvojich časových preferencií, kedykoľvek počas roku. Stačí sa nám ozvať na kariera@drmax.sk, radi Ti zodpovieme akékoľvek zvedavé otázky. Viac info nájdeš tu:


Jsme síť moderních lékáren, která je součástí zdravotnické skupiny EUC. Sídlíme většinou přímo v EUC Klinikách, což v praxi znamená, že odborná a poradenská část lékárnické profese je u nás na prvním místě
EUC Lékárny najdete v těchto městech: České Budějovice, Frýdlant, Hluboká nad Vltavou, Hradec Králové, Chrást, Kladno, Liberec, Olomouc, Ostrava, Pardubice, Plzeň, Praha, Přelouč, Slaný, Ústí nad Labem, Zlín kariera@euc.cz
Proč se v EUC líbí kolegům, kteří už u nás pracují?
Z dotazníku, který jsme kolegům poslali, vyplývá, že se jim v EUC líbí přátelská atmosféra a dobré mezilidské vztahy. Oceňují, že mají dostatek volného času a mohou dobře sladit práci a soukromí. A váží si toho, že pracují v prostředí, kde má prostor odborná část lékárenské práce.

Odborné konzultace v našich lékárnách:
• lékové poradenství
• odvykání kouření
• testování paměti
• použití inhalátoru
EUC je zdravotnická skupina, kterou tvoří kliniky, laboratoře a lékárny V oblasti ambulantní péče, mamografie a prémiové péče jsme vůbec největší soukromou společností na trhu. Provozujeme 25 klinik, 11 laboratoří, 13 mamocenter, 24 lékáren, e-shop a službu Lékař online 24/7
Lékárny

• U všech vypsaných pozic máte možnost práce na HPP, částečný úvazek či DPP/DPČ
• Respektujeme preskripci lékaře
• Magistraliter příprava v laboratoři lékárny
• 6 týdnů pracovního volna
• Poskytujeme prostor pro odbornou lékárenskou práci
• Nadstandardní zdravotní péče pro vás i rodinné příslušníky
• Podporujeme vzdělávání – včetně přípravy na atestaci
• Zaměstnanecké slevy v lékárnách
• Proplácíme členský poplatek ČLnK
• Neomezená online knihovna od vydavatelství Grada Publishing
• Peněžitý příspěvek na stravování
• Multisport karta
• Pestrá náplň práce a přátelská atmosféra v lékárně
• Lékárny jsou součástí klinik
• Máme volné víkendy
Studentům farmacie nabízíme možnost praxe v EUC Lékárnách. Většina našich lékáren je součástí EUC Klinik. Lékárníci zde úzce spolupracují s lékaři a konzultují s nimi lékovou problematiku, dostupnost léčiv a jejich případnou náhradu. Farmaceuti u nás jsou nedílnou součástí odborných týmů klinik!





• Individuální přístup a vedení zkušeným lékárníkem
• Praktické dovednosti pro budoucí praxi lékárníka
• Pestrou přípravu IPLP v plně vybavených laboratořích
• Spolupráci s týmem farmaceutů i lékařů
• Odborné projekty, konzultační činnost a další vzdělávání
• Finanční ohodnocení praxe
• Výdej léků na recept, zdravotnických prostředků i volně prodejného sortimentu včetně praktické legislativy, poskytování dispenzačních minim.
• IPLP přípravu jednotlivých lékových forem včetně posouzení receptur, lékárenských výpočtů, inkompatibilit a dalších.
• Ovládat sortiment lékárny, způsoby objednávání, přejímku zboží, kontrolu šarží a expirací, kusovou kontrolu, skladové hospodářství.
• Pochopit výši úhrad, cenotvorbu a ekonomiku lékárny v praxi.
• Vedení evidence léčivých přípravků i léčivých látek s obsahem omamných a psychotropních látek
• Odbornou administrativu včetně retaxace, přípravy dávek pro zdravotní pojišťovny, fakturace, archivace receptů, inventur aj.
• Poskytování konzultační činnosti v praxi, edukaci pacientů a podporu jejich zdraví.
VÍCE
NA NAŠEM
KARIÉRNÍM
WEBU:







Je to vzdelávanie určené pre farmaceutov, ktorého cieľom je edukovať personál v lekárňach o správnom používaní produktov Curaprox v prepojení na rôzne ochorenia. Farmaceuti následne dokážu lepšie a adresnejšie poradiť svojim pacientom. Vzdelávanie prebieha teoretickou a praktickou formou prispôsobenou cieľovej skupine.
Celoslovenský osvetový program, ktorý v spolupráci so študentmi zubného lekárstva či farmácie učí deti, ako sa správne starať o zuby a pomáha tak vytvárať správne návyky v starostlivosti o chrup.
iTOP
Vzdelávacie podujatie iTOP – individuálne trénovaná orálna profylaxia – privádza dentálnych odborníkov na cestu prevencie, ktorá je kľúčom k modernej stomatológii. Skladá sa z teoretickej časti a nácviku čistenia zubov. Účastníci sa nenaučia len nové poznatky a techniky, ale aj to, ako ich efektívne posúvať na pacientov a robiť tak odborníkov aj z nich.
Ak chcete dať vysokoškolskej kapitole ďalší rozmer, Curaprox má pre vás skvelú príležitosť – staňte sa školiteľmi projektu Dental Alarm. Ten učí žiakov v školách a škôlkach, ako sa starať o zuby správne, pravidelne a s radosťou.
Pomáhajte deťom a tínedžerom k zdravším úsmevom, privyrobte si naozaj zmysluplným spôsobom a popri tom zbierajte parádne zážitky.
Čo vás čaká?
• mzda: junior školiteľ/ka 8 €/hod, senior školiteľ/ka 10 €/hod
• firemné auto na cesty za školením preplatené cestovné náklady a čas strávený na ceste zľavu 35% na všetky produkty Curaprox



Unikátne remineralizačno-antibakteriálne zloženie novej ochrannej peny Curaprox dokáže zásadným spôsobom pomáhať pacientom v rôznych situáciách:
• predchádzanie kazivosti pri nosení neviditeľného strojčeka
• predĺženie efektu po dentálnej hygiene či bielení zubov
• zmiernenie problému suchých úst
• pomoc pri mykózach v ústach
• zmiernenie problému citlivých zubov
Čím je výnimočné zloženie peny Curaprox?
Vysoký obsah minerálu hydroxyapatit remineralizuje a regeneruje zubnú sklovinu. Prírodné enzýmy dopĺňajú ochrannú funkciu slín. Látka magnolol účinkuje proti baktérii spôsobujúcej zubný kaz a aj proti mykóze v ústach. Citrox®, cyklodextríny a xylitol významne zvyšujú antibakteriálny účinok.
Zloženie je jemné, nedráždivé a neobsahuje laktózu.























100 tbl

Zinok prispieva k udržaniu zdravých vlasov, nechtov a pokožky, k plodnosti a správnej reprodukčnej funkcii. Napomáha k správnemu fungovaniu imunitného systému , k normálnej syntéze DNA, deleniu buniek a ich ochrane pred oxidačným stresom.
bez laktózy bez lepku
bez cukru veggie



balenie obsahuje




60 cps

Vitamín C s postupným uvoľňovaním prispieva k normálnej funkcii imunitného systému, k zníženiu miery únavy a vyčerpania a k normálnej tvorbe kolagénu. Taktiež prispieva k ochrane buniek pred oxidačným stresom a zvyšuje vstrebávanie železa.
bez laktózy bez lepku
bez cukru veggie

balenie obsahuje







60 cps

Vitamín D prispieva k správnemu fungovaniu imunitného systému, k udržaniu zdravých kostí, zubov a správneho fungovania svalov. Prispieva k normálnej hladine vápnika v krvi a jeho správnemu vstrebávaniu.
bez laktózy bez lepku bez cukru

Nájdete v sortimente UNIPHARMY




balenie obsahuje




60 tbl




Diosmín komplex obsahuje mikronizovaný diosmín a hesperidín. Prispieva k zmierneniu pocitu ťažkých nôh.
balenie obsahuje
bez laktózy bez lepku
bez cukru veggie





Aescín 30 mg



60 tbl


balenie obsahuje
150 ml
Kalciový sirup s vitamínom D, príchuť lesná jahoda



Výživový doplnok. Výživový doplnok.




+ Vitamín C 24 mg
balenie obsahuje
Na zmiernenie pocitu ťažkých nôh. Prispieva k normálnej tvorbe kolagénu a správnej funkcii krvných ciev. Prispieva k ochrane buniek pred oxidačným stresom.
bez laktózy bez lepku
bez cukru veggie



Kalciový sirup s vitamínom D obsahuje vápnik, ktorý je potrebný na udržanie zdravých zubov a kostí Vitamín D prispieva k správnemu vstrebaniu/využitiu vápnika a fosforu.

Vhodný pre deti od 3 rokov.
bez laktózy bez lepku veggie




Rutín 25 mg
60 tbl


bez cukru veggie



+ Vitamín C 60 mg
Prispieva k normálnej tvorbe kolagénu a správnej funkcii krvných ciev. Prispieva k ochrane buniek pred oxidačným stresom.
bez laktózy bez lepku






Ak sa rozhodneš pre kariéru v Lekárni Vesnala, nikam chodiť nemusíš. Vážime si každého šikovného farmaceuta, preto ti do práce nebudeme zbytočne kecať. U nás máš podmienky, aké si zaslúžiš.
Nástupný bonus až do 5 000 €
Dvojnásobné príplaky za víkend
Príspevok na svadbu a narodenie dieťaťa
Príspevok na cestovanie
Narodeninový a vianočný bonus
Preplatenie poplatkov do lekárnickej komory
Viac o práci v Lekárni Vesnala nájdeš na kariera.vesnala.sk
Multisport kartička
Teambuildingové aktivity
Martin
Brezno Chorvátsky Grob
3x Trnava
3x Bratislava
Nové Zámky
Hoci pod novým názvom Vesnala nás poznáte len chvíľu, prvú lekáreň sme otvárali ešte v roku 2010. Odvtedy máme už 10 prevádzok a pribúdajú ďalšie. Pracujeme v malých tímoch, kde panuje rodinná atmosféra a do práce sa preto vždy tešíme. Veríme štyrom hodnotám, a tými sú sloboda, férové podmienky, osobitý prístup a otvorenosť.
Sloboda
Vy sami si určíte, ako budete pracovať, od výberu zmeny až po rozhodnutie, aký liek či produkt budete expedovať.
Férové podmienky
Sme transparentní, preto si spolu nastavíme férové platové aj bonusové podmienky.
Osobitý prístup
Vážime si jedinečnosť každého kolegu, či už je sanitár, alebo odborný zástupca lekárne.
Otvorená komunikácia
Máš nápad na zlepšenie?
Potrebuješ riešiť nejaký problém?
Sme tu, zaujímame sa a počúvame.
 Marek Ragač CEO
Marek Ragač CEO
+421 904 689 533 marek.ragac@vesnala.sk

+421 901 744 443
barbora.kolejakova@vesnala.sk

Na čo sa môžete tešiť?
Zo spoločnosti Zentiva Vás privítajú:

• Na veľa informácií od našich kolegov ohľadne kariérnych možností. Mnohí z nich sú absolventmi Vašej školy.
• Na prednášku o príbehu zamestnávateľa, ktorý ponúka miesto pre sebarealizáciu.
• Na množstvo ďalších informácií a odpovedanie na Vaše otázky.

Mgr. Matúš Uličný, Sales Director
Mgr. Samuel Medvecký, PMO/Digital Manager
PharmDr. Lenka Zálešáková, Medical representative; Mgr. Silvia Šimonová, Medical Representative; Mgr. Ľubomíra Petényi, HR Admin& Payroll Manager; PharmDr. Matej Fábry, Affiliate Quality Manager/Responsible Pharmacist; Mgr. Patrícia Medvecká, Regulatory Affairs Specialist ; Mgr. Alžbeta Kráľovičová, Regulatory Affairs Specialist; Tímea Snováková , HR & General Services ; Lenka Nagyová, Executive Assistant GM
Slúžime
Náš obchodný model je založený na poskytovaní značkových, špeciálnych, voľnopredajných a generických liekov a liekov s pridanou hodnotou.


Vyvíjame
Spoločnosť Zentiva má dve výskumné a vývojovécentrá so sídlom v Prahe a v Ankleshwari, kde náš výskumný a vývojový tím vyvíja a riadi inovácie v oblasti formulácie liekov.
Vyrábame
Spoločnosť Zentiva má štyri výrobné závodypražský závod, bukureštský závod 1 a závod 2 a závodAnkleshwar, ktoré vyrábajú viac ako 50 % dodávok výrobkov spoločnosti Zentiva.
Staráme sa
Naším poslaním je zabezpečiť dodávky vysokokvalitných a cenovo dostupných liekov ľuďom, ktorí sú na ne každý deň odkázaní. Robíme to udržateľným spôsobom.
Naša história
Korene spoločnosti Zentiva siahajú 530 rokov dozadu k lekárni Čierny orol, malému podniku, ktorý slúžil obyvateľom Prahy.
Náš vedúci tím
Chceme sa uistiť, že našu spoločnosť riadia ľudia,ktorí sú správne vybraní na základe svojich kompetencií a zručností.









Zentiva založila a je hlavným partnerom výskumného inštitútu The Parc, ktorý má sídloa pôsobeniev pražskej centrále a ktorý ponúka postgraduálne školenia vo farmaceutickomvýskume, študentské stáže a výmenu vedeckého know-how. Parc ponúka akademickévzdelanie svetovejtriedy v kombinácii s praktickými skúsenosťamiz priemyslu a obchodupod vedenímvedcov,inžinierov a manažérov z akademickej obce a farmaceutického priemyslu.
Zentiva aktívne spolupracuje s domácimi výskumnými inštitúciami a univerzitami.


Magnézium v organickej forme s vysokou vstrebateľnosťou:
prispieva k uvoľneniu napätia a redukcii kŕčov
znižuje stres a podporuje kvalitný spánok
neobsahuje laktózu ani sacharózu
podporná liečba pri vysokom krvnom tlaku

*



+ Praxe na míru

Vybereme ti lékárnu přesně podle tvých představ. Ať už tě lákají streetové lékárny, OCéčka, polikliniky a nebo tady najdeš i největší centrální laborat
Získáš přístup k nejnovějším e-learningovým k školením a konferencím Akademie Dr. Max zd
+ Bezstarostné bydlení
Pomůžeme ti najít ubytování a přidáme ti měs (cca 82,5 EUR) na nájem. Bez stresu z hledán
+ Finanční bonus
Na praxi v Praze získáš 24 000 Kč (cca 990 EU v hrubém za 160 hodin praxe). A to vše bez zá
+ Erasmus
Využij program Erasmus+ a prožij praxi naplno Se všemi formuláři ti rádi pomůžeme.
Podívej se, co o praxi říkají tvoji spolužáci. :)



Zní to dobře? To máme radost! Přihlásit se můžeš jednoduše zde.
kontaktovat.
 Pokud máš zájem o jinou lokalitu, neváhej mě
Pokud máš zájem o jinou lokalitu, neváhej mě
Přidejte se k nám!

České Budějovice, Domažlice, Rakovník, Chomutov, Karlovy Vary, Ústí nad Labem, Plzeň, Žatec a Teplice.
+ Průměrná mzda 2 500 EUR měsíčně

+ navíc 400 EUR měsíčně nebo služební auto na 2 roky
Náborový příspěvek 8 000 EUR
+ Podpora kariérního růstu
Příspěvek na bydlení 280 EUR měsíčně
Při atestaci Vám uhradíme 80% nákladů spojených s účastí na potřebných školeních a k tomu získáte 10 dní placeného studijního volna.
+ Špičkové vzdělávání
Budete mít přístup ke stovkám e-learningových lekcí a vstup zdarma na Akademii Dr. Max.
+ Mnoho benefitů
5 týdnů dovolené, Multisport karta, stravenky ve výši 7,50 EUR, pracovní oblečení a další standardní benefity.
Více info zde

Príde čas, kedy každý z Vás bude stáť pred asi najdôležitejším rozhodnutím
Vášho života Budete hľadať jasné a pravdivé odpovede na otázky, kým ste dnes a kým chcete byť zajtra; čo chcete dosiahnuť a aký život žiť; v čo veríte a za čo sa postavíte; a ktorým smerom sa vydáte po ukončení vysokej školy
Už ste určite počuli, že Vaše rozhodnutie je vo Vašich rukách, ale po ukončení štúdia príde práve tá pravá chvíľa, kedy pôjde viac ako len o Vaše rozhodnutie; pôjde o Vašu budúcnosť, dosiahnutie Vašich cieľov a naplnenie
Vašich ambícií
Je to Váš život a Vy máte možnosť voľby Nejde iba o to, kde budete bývať a akú prácu budete mať. Ale aký život budete viesť.
Skutočný úspech sa nemeria iba prácou, ktorú robíte Meria sa prácou, ktorá sa stáva súčasťou Vášho života Robí Vás lepšími Nadchýna Vás Prináša Vám radosť a profesionálne naplnenie. Je to niečo, o čo sa všetci snažíme ☺
V našej spoločnosti Vám pomôžeme realizovať Vaše ambície. Pracovať v tíme, kde sa ľudia rešpektujú navzájom, vedia sa spolu tešiť, pomáhať si a neboja sa prekážok
Pretože vieme, že úspech firmy spočíva v rozvíjaní potenciálu jednotlivých zamestnancov, významnú pozornosť venujeme adaptácii a osobnému rozvoju našich ľudí













SpoločnosťGlenmarkPharmaceuticalsLtd.bolazaloženávroku1977vIndii.Glenmark Pharmaceuticalsjecelosvetovopôsobiacanadnárodnáintegrovanáfarmaceutická spoločnosťsosídlomvMumbaji,kdesanachádzaajvýskumnáavývojovázákladňa spoločnosti.
GlenmarkPharmaceuticalsLtd.aktuálnepôsobívoviacako80krajináchsvetaaroku1998je CEOcelejspoločnostiGlennSaldanha.
Vroku2007sauskutočnilaakvizícia,priktorejGlenmarkPharmaceuticalsLtd.získalčeskú spoločnosťMedicamenta.SúčasťouakvizíciebolajvýrobnýzávodspoločnostiMedicamenta voVysokomMýte.VoVysokomMýtesarealizujevýroba,prepúšťanieafinálnebalenie množstvaliekovavýživovýchdoplnkovprecelýregiónEurópskejúnie.
Odapríla2009našafirma,ktorámalapredtýmnázovMedicamenta,vystupujepodnovým názvomGlenmarkPharmaceuticalss.r.o.sosídlomvPrahea GLENMARK PHARMACEUTICALSSK,s.r.o.vBratislave.
GlenmarkPharmaceuticalsjezameranýnapriekopníckeobjavovanienovýchliekov predovšetkýmvoblastizápalu(CHOCHP/astma,reumatoidnáartritída,atď.),metabolických porúch(cukrovky,obezityatď.)abolesti(neuropatickejazápalovejbolesti).Množstvo potenciálnychnovýchliekovjevrôznychfázachpredklinickéhoaklinickéhovývoja.
VsúčasnejdobesaspoločnosťradímedziTOP80svetovýchpharmaabiotechnologických spoločností(podľarebríčkaSCRIP1002019).Vroku2011bolGlenmarkvybranýako „najlepšiaspoločnosťnarozvíjajúcichsatrhoch“azískaluznanieza„BestOverallPipeline 2011″odSCRIP,najrešpektovanejšiehofarmaceutickéhočasopisunasvete.Glenmarkje globálnouavedúcoufarmaceutickouspoločnosťouzaloženounaintegrovanomvýskume.
Základfiremnejkultúrytvoriazamestnanci,ktorívyznávajúnašehodnoty:
Wevaluetheachievementof objectivesandconsistently strivetowardsourvision,with preservence.
Werespectallour stakeholders.
Tomášikova64,Bratislava,(Lakesidepark)
+421220255041
info@glenmarkpharma.com
www.glenmarkpharma.sk
Wevalueknowledgesuchthat itempowersourpeopletofind innovativesolutionsto managechange.
























































































IQVIA je medzinárodným lídrom v oblasti informatiky v zdravotníctve a riešení pre farmaceutický priemysel.
V tejto oblasti poskytujeme špičkové služby, ktoré pomáhajú našim zákazníkom zlepšovať kvalitu života a zdravotný stav pacientov na celom svete.
Naša rozsiahla ponuka služieb zahŕňa klinické štúdie, skúsenosti z reálneho sveta, poradenstvo v oblasti regulácií a ďalšie.
Vďaka našim údajom, analytickým nástrojom a odbornému zázemiu pomáhame našim zákazníkom vytvárať efektívne stratégie a dosahovať ich ciele.

Andrea, vieme, že si absolventkou farmaceutickej fakulty. Môžeš nám prezradiť, ako si sa k tejto práci dostala a ako si sa dozvedela o spoločnosti IQVIA?
O spoločnosti IQVIA som sa dozvedela na Kariérnych dňoch farmaceutov. Práca monitorky je veľmi zaujímavá a dynamická. Ako monitor mám na starosti konkrétne štúdie a centrá klinického výskumu. Mojou prácou je dohliadať na to, aby štúdia prebiehala v súlade s protokolom a správnou klinickou praxou. Centrá navštevujem osobne a vďaka tomu mám možnosť precestovať celé Slovensko. Pred každou vizitou je dôležitá dôkladná príprava a po vizite podrobná správa o aktuálnom stave centra.
Ako vyzerá Tvoj deň?
Každý inak. Aj preto je pre mňa táto práca zaujímavá. Prácu by som rozdelila na dni na centre a mimo centra. Pokiaľ mám vizitu na centre, tak sa venujem pacientskej dokumentácii, kontrole liekov, ich správnemu skladovaniu. Ďalej sledujem, či centrum vykonalo všetky procedúry a vyšetrenia v súlade s protokolom štúdie a správnou klinickou praxou. Dni mimo centra sú viac o administratíve – je potrebné spísať všetky výstupy z vizity do správy. V prípade nájdených chýb alebo nezrovnalostí komunikujem s projektovým tímom, klinickým lídom, centrom a hľadáme riešenia na čo najrýchlejšie odstránenie problému. Dôležitou súčasťou práce je aj príprava na ďalšie vizity, študovanie dokumentov a protokolu. Monitor je osobou prvého kontaktu pre centrum a preto sa dni odvíjajú aj od toho, ako často zazvoní telefón.
Bolo vždy Tvojím prianím pracovať v oblasti klinického výskumu?
Práca monitora ma oslovila ešte počas štúdia na farmaceutickej fakulte. Približne od druhého ročníka som vedela, že by som chcela byť monitorka. Zaujalo ma, že ako farmaceut viem svoje vedomosti využiť aj pri klinickom výskume liečiv. Páčila sa mi aj predstava, že viem prácu spojiť s cestovaním po krajine.
Práca monitorky klinických skúšaní vyžaduje veľa organizačných a komunikačných schopností. Máš návod ako sa to všetko dá zvládnuť?
Už štúdium na farmaceutickej fakulte ma pripravilo na organizáciu môjho času. Je dôležité určiť si priority a naplánovať činnosti. Musím sa priznať, že je to niekedy náročné. Najmä keď mám niečo naplánované a musím plány zmeniť kvôli aktuálnej urgentnej situácii. Flexibilita je pri práci monitora veľmi dôležitá.
Čo Ťa na tejto práci najviac uspokojuje a motivuje pokračovať?
Vízia, že pomáham pacientom a aj vďaka mojej práci sa dostávajú inovatívne lieky bližšie k ľuďom. V konečnom dôsledku pacient, jeho zdravie a bezpečnosť, sú vždy na prvom mieste. Ďalej sa mi na mojej práci páči, že mám priestor rozvíjať sa – či už v rôznych terapeutických oblastiach alebo v nových procesoch, ktoré štúdie prinášajú. Klinické skúšanie je veľmi dynamický proces, ktorý so sebou prináša častokrát veľké výzvy, ale aj pocit zadosťučinenia, že robíme svet pre pacientov lepším.
Ďakujem, Andrea, za rozhovor, a prajem Ti ešte veľa ďalších úspešných projektov a spokojnosti v práci monitorky.






Sme slovenský veľkodistribútor. Našim predmetom činnosti je distribúcia humánnych a veterinárnych liekov, zdravotníckych pomôcok, kozmetiky, diagnostík, homeopatík a doplnkového sortimentu Naším poslaním je zabezpečiť dostupnosť liekov pre slovenského pacienta. Sme stabilná spoločnosť, ktorá funguje na Slovensku už od roku 1991.
Značka Som farmaceut podporuje odbornú rolu farmaceuta v spoločnosti a má byť nádejou uvedomenia si, že farmaceut je pomáhajúca profesia a zdravotnícky pracovník, ktorý je pripravený pacientovi pomôcť profesionálne a odborne. Je synonymom hrdosti pre pomoc iným, odbornosti a pozitívnej nálady.
Sme vlastnený individuálnymi nezávislými majiteľmi a spája nás spoločná obchodná a marketingová stratégia. Lekárňam patriacim pod značku Vaša Lekáreň pomáhame v oblasti: vzdelávania, udržania si pacientov a prilákania si nových zákazníkov do lekárne, usporiadania lekárne a zárobku v lekárni. Vaša Lekáreň prevádzkuje aj internetovú lekáreň vasalekaren.sk a službu Online rezervácia liekov.
TOTO je naša privátna značka výživových doplnkov. Kvalita je základným pilierom značky, ktorá je zapísaná v DNA od úplných začiatkov. Na výrobu produktov používame kvalitné európske suroviny podložené klinickými štúdiami.























Advanced Training In Pharmacy Care
Farmaceutická fakulta UK, Slovenský spolok študentov farmácie a farmaceutická spoločnosť Wörwag Pharma Slovensko s.r.o. v 9. ročníku projektu ponúkajú




získanie vedomostí a hlavne praktických zručností pred nástupom do praxe,
skvalitnenie dispenzačnej a poradenskej činnosti pri liečbe aj samoliečbe pacientov,
vytvorenie úspešnej a dlhoročnej spolupráce akademického a podnikateľského subjektu.
PRE KOHO JE URČENÝ?
pre maximálne 7O študentov 4. ročníka
2-dňový tréning zameraný na získanie odborných a praktických zručností v oblasti správnej dispenzačnej praxe orientovanej na pacienta, apríl/2O24 , na našej fakulte praktická časť projektu , október/2O24 , v mieste výkonu Tvojej praxe
PredsedaGENAS:PharmDr.MichaelaPalágyi,PhD.
Biologickypodobnéliekyniesútotožnésgenerickýmiliekmi(liek,ktorýobsahuje presnetúistúmolekuluakoexistujúcinebiologickýliek,napríkladaspirín).Jeto preto,lebonarozdielodnebiologickýchliekovnemožnobiologickéliekypresne skopírovať(1).
Biologickypodobnéliekysúvyvinutétak,abyboliveľmipodobnéexistujúcemu biologickému referenčnému lieku Malé rozdiely sa vyskytujú pri všetkých biologickýchliekoch,dokoncaajmedzirôznymišaržamitohoistéhoreferenčného lieku.Tietorozdielysúdanétým,žeúčinnélátkysúveľkéakomplexnémolekuly vytvorené živými bunkami (obr 1) Biologicky podobné lieky sú vyrábané biotechnologickyauvádzajúsanatrhpovypršanípatentovejochranybiologického referenčnéholieku.
Obrázok 1: Typy proteínov biologických liekov registrovaných v EÚ (inzulín, rastový hormón, monoklonálna protilátka) (2)




Tak,akoprikaždominomlieku,ajpribiologickypodobnomlieku,jepredjeho schválenímpreuvedenienatrhpotrebnépreukázať,žejehoprínosyprevažujúriziká. Vyžadujesitoveľkémnožstvoúdajov,vrátaneúdajovtýkajúcichsačistotyavýroby, akoajsprávnehofungovaniabiologickypodobnéholiekuatiežrozsiahleporovnanie s referenčným biologickým liekom. Porovnania sa vykonávajú postupným spôsobom,ktorýsazačínapodrobnýmifyzikálno-chemickýmištúdiamivlaboratóriu, priktorýchsaporovnávaštruktúrasfunkciouliekov,anáslednesapodľapotreby prechádzanaporovnávacieklinickéštúdie(štúdienaľuďoch).
Vzhľadomnaspôsob,akýmsabiologickypodobnéliekyvyvíjajú,niejevždypotrebné uskutočňovaťklinickéštúdieobiologickypodobnomliekuprivšetkýchochoreniach, priktorýchsapreukázalaúčinnosťreferenčnéhobiologickéholieku.Namiestotoho je niekedy možné rozšíriť údaje o bezpečnosti a účinnosti zo štúdií jedného ochorenia na ostatné chorobné stavy Tento postup je známy ako extrapolácia Rozhodnutieotom,čisanaliečbuďalšíchstavovbudúvyžadovaťnovéklinické štúdie, prijíma Európska agentúra pre lieky (EMA) podľa jednotlivých prípadov, pričomvychádzazvedeckýchdôkazov.



Po kladnom posúdení zo strany EMA schváli Európska komisia biologicky podobnýlieknapoužívanieupacientovvEÚ(1)
Biologická liečba sa používa v onko-hematológii, gastroenterológii, reumatológii, onkológii, dermatológii Najviac skúseností s biosimilárnymi liekmi majú na Slovensku pacienti so zápalovými ochoreniami tráviaceho traktu, reumatickou artritídou a onkohematologickí pacienti. OnkohematologickípacientinaSlovenskusúliečeníbiosimilárnymiliekmiuž odroku2009t.j.14rokov.
Nadomácomtrhusúniektorémolekulyakonapr.erytropoetín,filgrastim,kde saužreferenčnýliekaninepoužíva,aleliečisaibabiosimilárom Skúsenosti s používaním biologicky podobných monoklonálnych protilátok (napr. infliximab)súodroku2013.
Biologickypodobnéliekysúrovnakoúčinnéabezpečné,alesdostupnejšou cenou,nakoľkonemajútakévysokénákladynavýskumavývojakoreferenčné biologikum(3).
Vzáujmeznížiťverejnévýdavky,resp.zvýšiťdostupnosťbiologickejliečbypre viacpacientov,viacerízahraničníautoriodporúčajúpodklinickýmdohľadom intenzívnejšie využívanie dostupnejších biosimilárnych liekov pri liečbe nových, ako aj už liečených pacientov. Podľa štúdie Európskej liekovej agentúry(EMA)zroku2017sazaposledných10rokovnepreukázalrelevantný rozdielvnežiaducichúčinkochmedzireferenčnýmiabiosimilárnymiliekmi(1).
Navyše EMAvseptembri2022vydalaspoločnévyhláseniesHMA(Headsof



Lekárnické listy
Odborno-informačný mesačník Slovenskej lekárnickej komory prináša informácie o aktuálnych legislatívnych zmenách, odborné príspevky, reportáže zo vzdelávacích podujatí a rozhovory.
Slovenský lekárnik
Odborný časopis slovenského lekárenstva venovaný histórii s cieľom poukázať na bohaté dejiny a významné osobnosti lekárenstva a farmácie. Periodikum nadväzuje na kedysi vydávaný časopis s názvom Slovenský lekárnik, ktorý vydával Zväz lekárnikov Slovákov od roku 1931 do roku 1951.
Kto má kľúče od skrinky s jedmi?
Publikácia sa venuje správnemu použitiu liekov v domácom prostredí. Obsahuje vybrané skupiny najčastejšie používaných skupín liekov pri liečbe bolesti, horúčky, prechladnutia, kašľa, ochorenia gastrointestinálnych traktu, vrátane rizík spojených s užívaním liekov neviazaných na lekárskych predpis.
Lieky počas dojčenia – kedy áno, kedy nie ...
Publikácia sa venuje špecifikám farmakoterapie počas dojčenia so zameraním na tieto skupiny liekov: analgetiká, antipyretiká, antimigreniká; antidepresíva, anxiolytiká, hypnotiká, sedatíva; antiepileptiká; H1 antihistaminiká; antihypertenzíva; antibiotiká; antimykotiká; lieky používané pri akútnej infekcii horných dýchacích ciest; lieky ovplyvňujúce gastrointestiálny trakt a kontraceptíva.
Dieťa nie je malý dospelý
Publikácia sa venuje špecifikám farmakoterapie detských pacientov. Prehlbuje poznatky v problematike farmakoterapie v detskom veku s dôrazom na špecifické odlišnosti v jednotlivých vekových kategóriách.
Bezpečná farmakoterapia seniorov
Publikácia sumarizuje zvláštnosti v používaní liekov u starších ľudí. Charakterizuje starnutie a problémy u starších ľudí. Približuje špecifiká farmakoterapie a problémy v terapii starších ľudí a ich riešenie. Súčasťou publikácie je aj kapitola venovaná liekom vydávaným bez lekárskeho predpisu v terapii starších ľudí.
Nie je odpad ako odpad
Publikácia prináša základné informácie o vplyve liečiv na životné prostredie, ich prestup do poľnohospodárskych plodín a potenciálne riziko pre človeka. Obsahuje príklady environmentálnych kampaní v prostredí lekárne a cennou súčasťou publikácie je spracovanie právnych súvislostí zneškodňovania nespotrebovaných humánnych a veterinárnych liekov.
Nesteroidné antiflogistiká a paracetamol v samoliečbe bolesti a horúčky
Publikácia prináša ucelené zázemie vedomostí v súlade s medicínou založenou na dôkazoch pre každého farmaceuta, ktorý by sa rád lepšie zorientoval v problematike použitia analgetík-antipyretík v samoliečbe.
Manuál receptúr pre individuálnu prípravu liekov v nemocničných a vo verejných lekárňach
Príprava liekov je už oddávna kľúčovou zručnosťou farmaceutov.
Manuál obsahuje 179 receptúr z osemnástich nemocničných lekární.
Pacient s kašľom v lekárni – čo hovorí EBM?
Akútny kašeľ predstavuje najčastejšie novovzniknuté ochorenie, pre ktoré pacienti vyhľadávajú zdravotnícku pomoc. Publikácia poskytuje ucelené a vyvážené informácie, ktoré môžu byť potrebné pre poskytovanie farmaceutickej starostlivosti o pacientov s kašľom.
Interakcie liekov – všeobecné aspekty
Interakcie liekov – kľúčové farmakologické skupiny
Interakcie liekov – riešenie vzorových prípadov a kazuistiky

Medzi tradičné vzdelávacie podujatia organizované alebo spoluorganizované Slovenskou lekárnickou komorou patria:
Bratislavské lekárnické dni
Stredoslovenské lekárnické dni
Liptovsko-oravské lekárnické dni
Zemplínske lekárnické dni
Kongres nemocničných lekárnikov
Etické a morálne aspekty povolania farmaceut
20 rokov zákona o liekoch a zdravotníckych pomôckach //
tetických potravín, alebo zdravotníckej pomôcky, ktorá je uvedená v zozname kategorizovaných zdravotníckych pomôcok;
Projekt interakcieliekov.sk
4. produkt vymedzený v bode 3 sa uhrádza na základe verejného zdravotného poistenia.
Na tomto mieste je potrebné zaoberať sa skutočnosťou, či úmyslom zákonodarcu bolo znením § 23 ods. 5 limitovať konzultačnú činnosť realizovanú lekárňou v zmysle § 20 ods. 1 písm. e) zákona o liekoch – teda či poradenská činnosť (a za akých podmienok) predstavuje napr. výhodu, ktorej poskytnutie § 23 ods. 5 zakazuje.
Pri reštriktívnom výklade konzultačnej činnosti lekárne by sme mohli ad absurdum dospieť k záveru, že za zakázané poskytovanie výhod možno považovať aj podrobné poučenie pacienta o liekoch, základnom a doplnkovom sortimente, zhovievavejší prístup personálu lekárne k pacientom v širšom rozsahu, ako je bežné v iných lekárňach v rámci informačnej a poradenskej činnosť lekárne pri výdaji Rx sortimentu uhrádzaného z verejného zdravotného poistenia.
ustanovenia nevylučuje, že zákazy v nej obsiahnuté zasahujú aj činnosti, ktoré tvoria súčasť lekárenskej starostlivosti – napríklad konzultačná činnosť (sa môže považovať za istý druh plnenia pacientovi).
S poukázaním na vyššie uvedené by bolo vhodné, aby zákonodarca zameral svoju pozornosť nielen na najviac exponované časti zákona o liekoch, ale vyčistil aj menej „sexi“ zákutia tejto normy a prispel k budovaniu právnej istoty u jej recipientoch.
JUDr. Ivan Humeník, PhD. h&h PARTNERS, advokátska kancelária s.r.o. Komora pre medicínske právo – MEDIUS
Je absolventom Právnickej fakulty Trnavskej univerzity v Trnave. Doktorandské štúdium absolvoval na Právnickej fakulte Univerzity Pavla Jozefa Šafárika v Košiciach.
Cieľom projektu je zvýšiť povedomie širokej verejnosti o liekových interakciách a predstaviť farmaceuta ako prvolíniového konzultanta problematiky liekových interakcií a lekárne ako relevantného zdroja akýchkoľvek informácií o liekoch. Súčasťou projektu je aktívny prístup do najväčšej databázy liekových interakcií pre lekárne. Databáza obsahuje takmer 600-tisíc citácií odbornej literatúry a podrobnú charakteristiku viac ako 160-tisíc potenciálnych liekových interakcií aj s ich klinickým významom a návrhom riešenia.
Projekt Magistraliter
Aj napriek použitiu teleologického a systematického výkladu normy nie je možné vzhľadom na súčasnú výstavbu § 23 ods. 5 úplne vylúčiť, že upozornenia pacienta v rámci compliance pacienta (za naplnenia podmienok uvedených vyššie) by mohli byť zo strany regulátora vyhodnotené ako poskytovanie výhod, prípadne poskytnutie nepeňažného plnenia pacientovi, ktoré je v zmysle § 23 ods. 5 zakázané.
Je partnerom v advokátskej kancelárii h&h PARTNERS, v ktorej od roku 2008 vykonáva advokátsku prax, členom World Association for Medical Law (WAML), členom Komory pre medicínske právo – MEDIUS, členom redakčnej rady odborného časopisu zdravotníckeho práva a bioetiky (MedLaw Journal) vydávaného Ústavom státu a práva Akademie věd ČR, v.v.i.
Cieľom projektu je podporiť modernú prípravu IPL v lekárňach. Na internetovej stránke www.slek.sk v časti „magistraliter“ nájdete zoznam receptúr pripravovaných v súčasnosti v mnohých lekárňach na Slovensku.
Javí sa, že primárnym účelom regulácie obsiahnutej v § 23 ods. 5 je zákaz medicínsky neodôvodneného zvyšovania spotreby liekov na strane pacientov a tým zvýšených nárokov na verejné zdroje. Súčasné znenie dotknutého ustanovenia je ale príliš široké a v snahe zabezpečiť dosiahnutie legitímneho účelu stanovuje nejasným spôsobom viacero druhov zákazov. Formulácia dotknutého
Interakcie_082018_TYP6 14. 8. 2018 20:53 Page 2
Okrem advokátskej praxe sa venuje aj akademickej činnosti. V rámci svojej praxe pôsobil vo viacerých neziskových organizáciách (Inforoma, Slovenský Helsinský Výbor, Občan a Demokracia, ETP Slovensko – Centrum pre udržateľný rozvoj).




www.interakcieliekov.sk



Kto má kľúče od skrinky s jedmi?
Lieky počas dojčenia – kedy áno, kedy nie...
Dieťa nie je malý dospelý
Vek nie je iba číslo...
Nie je odpad ako odpad
Cieľom kampaní je zapojiť farmaceutov a verejné lekárne do projektov zameraných na poskytovanie odborného poradenstva pri farmakoterapii špecifických skupín pacientov a vzdelávať širokú verejnosť o správnom skladovaní, užívaní aj zneškodňovaní liekov.
Obnovenie činnosti Lekárne u Salvatora
Poslankyne a poslanci Mestského zastupiteľstva hlavného mesta
Bratislava v roku 2022 väčšinou hlasov schválili nájom priestorov budovy bývalej lekárne Salvator, vrátane historického mobiliáru, neziskovej organizácii Lekáreň u Salvatora, n.o. zriadenej Slovenskou lekárnickou komorou.
Nezisková organizácia bude v objekte poskytovať lekárenskú starostlivosť sedem dní v týždni, ale aj prezentovať priestor oficíny a barokový lekárenský nábytok širokej verejnosti.







Nová Rožňavská 3 831 04 Bratislava
www.slek.sk
urad@slek.sk
Štátny ústav pre kontrolu liečiv je národná lieková agentúra, ktorej hlavnou činnosťou je zabezpečovať odborné hodnotenie liekov a zdravotníckych pomôcok a dohľad nad trhom v oblasti humánnej farmácie a drogových prekurzorov
Naši odborní zamestnanci dohliadajú na bezpečnosť, účinnosť a kvalitu liekov a tiež zdravotníckych pomôcok, ktoré sa dostávajú k slovenským pacientom
Máme dokopy šesť sekcií. Najviac farmaceutov pracuje na sekcii registrácie liekov, sekcii klinického skúšania liekov a farmakovigilancie a tiež na sekcii inšpekcie
Väčšina zamestnancov pracuje v sídle štátneho ústavu na Kvetnej 11 v Bratislave, pôsobnosť úradu je však celoslovenská. Pobočky sekcie inšpekcie sa nachádzajú v Topoľčanoch, Žiline, Zvolene a v Košiciach.
ŠÚKL úzko spolupracuje s národnými liekovými agentúrami ostatných členských štátov EÚ a tiež s Európskou liekovou agentúrou. Naše kolegyne a kolegovia sú súčasťou tímov, ktoré združujú odbornú špičku v rámci EÚ a sú členmi rôznych medzinárodných pracovných skupín či výborov
V rámci EMA sú to napríklad PRAC (Výbor pre hodnotenie rizík liekov), CHMP (Výbor pre lieky na humánne použitie), PDCO (Pediatrický výbor), HMPC (Výbor pre rastlinné lieky), CAT (Výbor pre lieky na inovatívnu liečbu) alebo COMP (Výbor pre lieky na zriedkavé ochorenia).